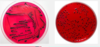
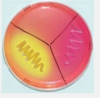
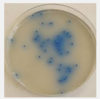

Lab Practicals Micro Flashcards
(57 cards)
Catalase
An enzyme produced by bacteria that respire using oxygen, and protects them from the toxic by products of oxygen metabolism. Catalase positive bacteria include strict aerobes as well as facultative anaerobes. It helps us differentiate between some gram positive bacteria.
Oxidase test
Used to determine if a bacterium produces certain cytochrome c oxidases. Only present in aerobic organizms. It is used to differentiate between some gram negative bacteria.
Microsporum canis
FUNGUS. Mycetoma (chronic subcutaneous infection). Most common cause of ringworm.
Zoophilic dermatophyte (animal- infection of the skin)- cats, dogs, horses, monkeys
Colonies are flat, spreading, white or yellow, dense cottony surface
Clinical significance: cause of ringworm in humans and skin lesions in animals- particularly dogs and horses.

What does oil immersion do?
Enables you to get very close to the specimen and allows you to get better magnification- you need transmitted light- dial up the light. Used with fixed specimens (staining and heating).
How can you ID yeast vs. bacteria?
Size and replicate by budding
What does gram stain do?
Allows you do ID gram neg or gram negative. And allows you to determine what type of antibiotic (more specifically)– though broad spectrum could be used on either. Also helps ID shape and allows you to begin to determine the type of organism.
What is acid-fast (or Ziehl-Neelsen) stain?
Used to ID mycobacteria (TB, Leprosy, Johne’s disease)– will hold the stain even when they’ve been decolorized with a strong solution.

What is Giemsa stain?
Aka Diff quick- blood smears- blood borne bacteria. Often stain differentially.
Trichophyton mentagrophyte var. mentagrophytes
Fungus. Zoophilic dermatophyte.
Mice, Guinea pigs, roos, cats, horses, sheep, rabbits
Animal bedding and food, floors, and soil.
Frow fairly fast- after 4-5 days
Small white, fluffy, button- colony spreads rapidly; can be diagnosed after 2-3 weeks. (Upper side cream to light under side dark brown)
Clinical significance: produces inflammatory skin lesions, nodular and tumourous lesions called kerions, most commonly seen in dogs.

How do you ID thin or small organisms?
Silver stain, dark field microscopy (look just at refracted light), electron microscopy (electrons have such a small wavelength)

What is one of the most sensitive ways to detect an organism?
Culture.
What is Sheep Blood Agar?
SBA is a nonselective medium and therefore allows the growth of a wide variety of organisms. It is used in the primary isolation of organisms from clinical specimens. (Pseudomonas aeruginosa- blue/green pigment and sweet odour, Streptococcus agalactiae- small colonies that are often beta haemolytic- i.e. complete lysis of sheep blood cells in the vicinity of the colonies, and Staphylococcus aureus- produce smaller colones compared to P. aeruginosa)
Peptides, salt, glucose, and sheep blood cells- nutrition that pathogenic bacteria like. Grow most common bacterial pathogens for vet medicine.
What is cell free media?
Cell free media- most bacteria will grow (has intert red cells)- can be broth (liquid) or solidified with agar.
Agar often preferred: you can see what they look like after they’ve grown. You can also spread out the bacteria in your sample so you can see the colony derived from a single bacterial cell.
* many different additives depending on nutritional req. of the organism
* Grow at different temperatures– usually we do 37C. However, this is under most animal’s body temperature. So it’s a habit from medical microbiology. Birds are even at 40C. There are some pathogens that will grow only at lower temps- ones that grow on the skin.
Penicillium species
Fungus.
Reservoir: air, house dust, plants; man and animal
Growth- quick, can be differentiated in just a few days
Powdery or velvety surface
Many colour tones- esp. green and blue green with FINE EXTENSIONS
Enlarged Lymph Nodes.

How do you grow a microaerophilic organisms?
Increase partial pressure of CO2 and decreased the partial pressure of O2- stick a candle in a jar- light the candle and put the culture in with it. Not anaerobic, but has more CO2 than O2.
Obligately intracellular parasites
ALL viruses and some bacteria- culture animal cells and grow them inside cells. Primary cultures freshly from an animal, established lines (easier to maintain in a lab- live in liquid nitrogen). Grown in complex media, often containing serum.
Aspergillus species
Fungus.
Reservoir: almost everywhere on every conceivable type of substrate; especially soil and decaying organic debris.
Growth- fast growing, recognizable within a few days.
Growth form- velvety to flaky surface due to marked sporulation
Color- white- yellow (A. flavus), grey- green (A. fumigatus), black (A. niger)
Clinical significance: A. fumigatus is the most common cause of all forms of invasive and non-invasive aspergillosis (nasal discharge- can be aggressive and cause turbinate destruction)


Trichophyton mentagrophytes var. mentagrophytes
Rhizopus sp.
High prevalence in sub tropical and tropical regions
Reservoir: isolated from many substrates including a wide variety of soils, decaying vegetation, foodstuffs, and animal and bird dung.
Growth- fast growing, colonies cover an agar surface with dense cottony growth, first white becoming grey or yellowish brown with sporulation.
Clinical significance: R. oryzae is the most common causative agent of cygomycosis (infection due to a member of the zygomycetes- aprophytic fungi)– accounting for some 60% of reported culture positive cases. Often used in the fermented foods and alcoholic beverages in Asia.

Epidermophyton floccosum
Antrhopophilic dermatophyte (prefers humans)
Commonsal, common shower or gym facilities
Growth- slow growing- suede-like surface, raised and folded in the center. Can develop white tufst of myslium.
Clinical significance: often causes tinea pedis (athlete’s foot), tinea cruris, tinea corporis (groin), and onychomycosis (fungla infection of the nail)- not known to invade hair invivo and no specific growth req. reported. Tinea= contagious skin fungal infection.

What is cytopathic effect (CPE)?
Viruses multiply in cells and in most cases cause CPE- i.e. the cell looks sick: inclusion bodies
Viral culture
Uninfected equine foetal kidney (EFK) culture and one that was infected with EHV1. Virus “plaque” formed by virus growth leading to lysis of the infected cells. Note the different morphology of the cells surrounding the plaque (infected) compared to cells away from it (uninfected).
* When EFK cells are infected with EHV1- the virus multiplies in the first cell it infects then spreads to neighboring ones forming a “focus” of infection. These foci slowly spread or enlarge until the entire cell culture is wiped out.

Nutrient agar
Like sheep blood agar it is a nonselective medium. It is less nutritious than SBA and therefore does not support the growth of the same variety of organisms. S. agalactiae is not supported on NA. Easier to view P. aeruginosa.
MacConkey’s Agar (MAC)
Commonly used to isolate and enumerate coliforms (gram negative organisms that inhabit the GI tract of mammals) and intestinal bacterial pathogens from a variety of sources including water, food, dairy products, and clinical specimen. Clinical specimen are typically placed on MAC and SBA in the initial steps of isolation.
It is an example of a SELECTIVE and DIFFERENTIAL medium.
The selective ingredient: bile salts. The aim is to inhibit organisms that do not tolerate the prescence of bile (GRAM NEGATIVE inhabit GI tract of mammals!).
Organisms that can grow on MAC are differentiated by their effect on neutral red, a pH indicator, which acts as an indicator for lactose fermentation. Pink (acid) colonies indicate that the organism is able to ferment lactose.
e.g. E. coli- lactose fermentation- yes!
Salmonella typhimurium- no lactose fermentation